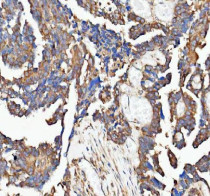

ARG44448
anti-PAIP1 antibody
anti-PAIP1 antibody for Flow cytometry,ICC/IF,IHC-Formalin-fixed paraffin-embedded sections,Western blot and Human
概述
| 产品描述 | Rabbit Polyclonal antibody recognizes PAIP1 |
|---|---|
| 反应物种 | Hu |
| 应用 | FACS, ICC/IF, IHC-P, WB |
| 宿主 | Rabbit |
| 克隆 | Polyclonal |
| 同位型 | IgG |
| 靶点名称 | PAIP1 |
| 抗原物种 | Human |
| 抗原 | Human PAIP1 recombinant protein |
| 偶联标记 | Un-conjugated |
| 別名 | PAIP1; Poly(A) Binding Protein Interacting Protein 1; PABP-Interacting Protein 1; Polyadenylate-Binding Protein-Interacting Protein 1; PAIP-1; Poly(A)-Binding Protein-Interacting Protein 1; PABC1-Interacting Protein 1 |
应用说明
| 应用建议 |
|
||||||||||
|---|---|---|---|---|---|---|---|---|---|---|---|
| 应用说明 | The dilutions indicate recommended starting dilutions and the optimal dilutions or concentrations should be determined by the scientist. |
属性
| 形式 | Liquid |
|---|---|
| 纯化 | Affinity purified with Immunogen. |
| 缓冲液 | 0.9% NaCl, 0.2% Na2HPO4, 0.05% Sodium azide and 4% Trehalose. |
| 抗菌剂 | 0.05% Sodium azide |
| 稳定剂 | 4% Trehalose |
| 浓度 | 0.5 mg/ml |
| 存放说明 | For continuous use, store undiluted antibody at 2-8°C for up to a week. For long-term storage, aliquot and store at -20°C or below. Storage in frost free freezers is not recommended. Avoid repeated freeze/thaw cycles. Suggest spin the vial prior to opening. The antibody solution should be gently mixed before use. |
| 注意事项 | For laboratory research only, not for drug, diagnostic or other use. |
生物信息
| 数据库连接 |
Swiss-port # Q9H074 Human Polyadenylate-binding protein-interacting protein 1 |
|---|---|
| 基因名称 | PAIP1 |
| 全名 | Poly(A) Binding Protein Interacting Protein 1 |
| 背景介绍 | The protein encoded by this gene interacts with poly(A)-binding protein and with the cap-binding complex eIF4A. It is involved in translational initiation and protein biosynthesis. Overexpression of this gene in COS7 cells stimulates translation. Alternative splicing occurs at this locus and three transcript variants encoding three distinct isoforms have been identified. |
| 生物功能 | Acts as a coactivator in the regulation of translation initiation of poly(A)-containing mRNAs. Its stimulatory activity on translation is mediated via its action on PABPC1. Competes with PAIP2 for binding to PABPC1. Its association with EIF4A and PABPC1 may potentiate contacts between mRNA termini. May also be involved in translationally coupled mRNA turnover. Implicated with other RNA-binding proteins in the cytoplasmic deadenylation/translational and decay interplay of the FOS mRNA mediated by the major coding-region determinant of instability (mCRD) domain. |
| 细胞定位 | Cytoplasm |
| 预测分子量 | 54 kDa |
| 翻译后修饰 | Acetylation, Methylation |
检测图片 (4) Click the Picture to Zoom In
-
ARG44448 anti-PAIP1 antibody IHC-P image
Immunohistochemistry: Human ovarian serous adenocarcinoma stained with ARG44448 anti-PAIP1 antibody at 2 μg/mL dilution.
-
ARG44448 anti-PAIP1 antibody ICC/IF image
Immunofluorescence: HeLa stained with ARG44448 anti-PAIP1 antibody at 5 μg/mL dilution.
-
ARG44448 anti-PAIP1 antibody WB image
Western blot: HeLa stained with ARG44448 anti-PAIP1 antibody at 0.5 μg/mL dilution.
-
ARG44448 anti-PAIP1 antibody FACS image
Flow Cytometry: SH-SY5Y stained with ARG44448 anti-PAIP1 antibody at 1 μg/10^6 cells dilution.